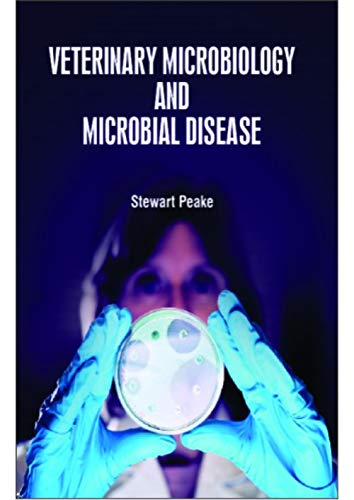
VETERINARY MICROBIOLOGY AND MICROBIAL DISEASE - Retail Maharaj

পশুচিকিৎসা মাইক্রোবায়োলজি এবং মাইক্রোবায়োলজিকাল রোগ
পশুচিকিৎসা মাইক্রোবায়োলজি এবং মাইক্রোবায়োলজিকাল রোগ is backordered and will ship as soon as it is back in stock.
Couldn't load pickup availability
Genuine Products Guarantee
Genuine Products Guarantee
We guarantee 100% genuine products, and if proven otherwise, we will compensate you with 10 times the product's cost.
Delivery and Shipping
Delivery and Shipping
Products are generally ready for dispatch within 1 day and typically reach you in 3 to 5 days.
লেখক: স্টুয়ার্ট পিক
ব্র্যান্ড: হোয়াইট প্রেস একাডেমিক
বাঁধাই: হার্ডকভার
প্রকাশের তারিখ: ০১-১২-২০২০
ইএএন: 9781799601449
প্যাকেজের মাত্রা: ১২.০ x ৮.৫ x ১.০ ইঞ্চি
ভাষা: ইংরেজি